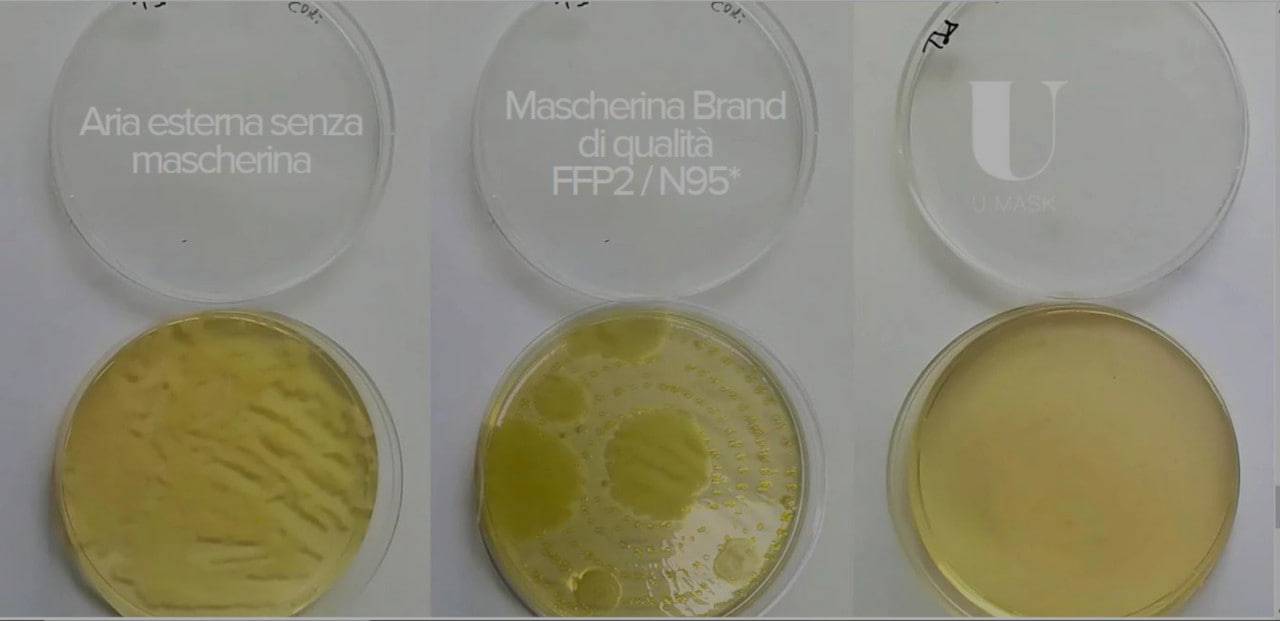

Sulle mascherine U-Mask interviene anche il Ministero della Salute: la decisione.

Vi abbiamo già parlato di U-Mask, unimamme, la mascherina in neoprene molto popolare tra i vip, che negli ultimi tempi è finita al centro di inchieste e denunce.
L’azienda U-Earth che produce questa particolare mascherina riutilizzabile, che avreste sicuramente visto sul volto di tanti personaggi famosi, era stata accusata di pubblicizzare le sue mascherine come dispositivi di protezione individuale (Dpi), quando invece erano state registrate presso il Ministero della Salute, per l’autorizzazione alla vendita, solo in conformità alla normativa sulle mascherine chirurgiche. Non dunque come un dispositivo medico, come le mascherine professionali Ffp2 o Ffp3.
Dopo l’intervento dell’Antitrust dei giorni scorsi, preceduto dal sequestro della Procura di Milano delle mascherine in alcune farmacie milanesi e dall’intervento dei Carabinieri del Nas in un laboratorio di Bilzano, arriva ora il provvedimento del Ministero della Salute.
LEGGI ANCHE: MASCHERINE CHIRURGICHE, QUANTE VOLTE POSSIAMO LAVARLE E RIUTILIZZARLE?
Mascherine U-Mask: il provvedimento del Ministero della Salute
Sulla discussa vicenda U-Mask interviene anche il Ministero della Salute con un provvedimento che dispone “il divieto di immissione in commercio del dispositivo medico U-Mask Model 2” e “l’adozione della misura del ritiro del medesimo prodotto” dal mercato.
Dunque, vietata la vendita nel modello 2 della mascherina U-Mask e ordinato il ritiro dal mercato. Misure severe che il Ministero della Salute ha deciso di adottare su segnalazione dei Carabinieri del Nas di Trento che avevano comunicato che le mascherine U-Mask venivano vendute come dispositivi medici in base a certificazione rilasciata da un laboratorio di analisi che” è risultato “privo di autorizzazione sanitaria e sottoscritta da un soggetto privo dei prescritti titoli abilitativi (non in possesso di laurea)”. Come riporta Repubblica.
Il Ministero ha sottolineato i “potenziali rilevanti rischi per la salute” derivanti “dall’assenza di un regolare processo valutativo” delle mascherine.
L’efficacia filtrante delle mascherine U-Mask
Da un’inchiesta del programma tv Striscia la Notizia, che aveva incaricato i laboratori BpSec per i test di sicurezza ed efficacia della mascherina, era risultato che U-Mask avrebbe una capacità di filtraggio sotto la soglia di legge e addirittura inferiore a quella di una comune mascherina chirurgica da 50 centesimi.
Eppure l’azienda produttrice U-Earth pubblicizza la sua mascherina vantando un capacità filtrante pari a quella dei dispositivi di protezione individuale (Dpi) come le mascherine professionali Ffp2 e Ffp3.
Proprio su questo aspetto era intervenuta l’Autorità Garante della Concorrenza e del Mercato (Antitrust), che aveva aperto un’istruttoria per pubblicità ingannevole e pericolosa nei confronti dell’azienda U-Earth. La sua mascherina U-Mask sarebbe priva delle caratteristiche indicate e della capacità filtrante pubblicizzata.
L’Antitrust avve annunciato di aver “avviato un procedimento istruttorio, nei confronti delle società U-Earth Biotech Ltd. e Pure Air Zone Italy S.r.l., per contestare le attività di promozione e di vendita delle mascherine ‘U-Mask’“. Attività che “sfruttando indebitamente la situazione di emergenza sanitaria in corso per indurre il consumatore a comprare a prezzi elevati il prodotto reclamizzato”.
A fine gennaio, oltre all’inchiesta della Procura di Milano, partita della denuncia di un’azienda concorrente, era stato sequestrato il laboratorio U-Mask a Bolzano dai carabinieri del Nas. La procura di Bolzano indaga sulla vicenda per l’assenza di autorizzazioni e per esercizio abusivo della professione.
Nel frattempo, a Milano è indagato l’amministratore della filiale italiana della società per frode nell’esercizio del commercio. La Procura ha incaricato un esperto, che avrà 40 giorni di tempo, per analizzare non solo le mascherine U-Mask, di cui sono stati sequestrati una quindicina di campioni per verificarne l’effettivo filtraggio, ma anche quelle dell’azienda concorrente dal cui esposto è stata aperta l’inchiesta.
I rischi per la salute
La Direzione generale dei dispositivi medici e del servizio farmaceutico del Ministero della Salute ha evidenziato la “irregolarità nel processo di immissione in commercio” delle mascherine U-Mask, che risultavano come dispositivi medici in base a certificazione di un laboratorio “privo di autorizzazione”, sottoscritta da un soggetto senza laurea. Pertanto ha sottolineato i potenziali rischi “in termini di sicurezza ed efficacia” e una “conseguente assenza di garanzia sull’effettiva adeguatezza come strumento di prevenzione dei contagi”.
Dunque, per “l’emergenza sanitaria in corso ed il conseguente acuirsi dei rischi” il provvedimento del Ministero ha “carattere d’urgenza”. Entro cinque giorni l’azienda dovrà ritirare i prodotti dal mercato a sue spese. L’ottemperanza alle disposizioni sarà verificata dai carabinieri del Nas. Il prodotto U-Mask viene “cancellato dalla Banca Dati dei dispositivi medici”. Comunque l’azienda potrà presentare ricorso allo stesso Ministero o al Tar.
LEGGI ANCHE: MASCHERINE, INDOSSARNE DUE RIDUCE IL CONTAGIO: LA CONFERMA DEGLI ESPERTI

Che ne pensate unimamme di questo provvedimento? Conoscevate la mascherine U-Mask?